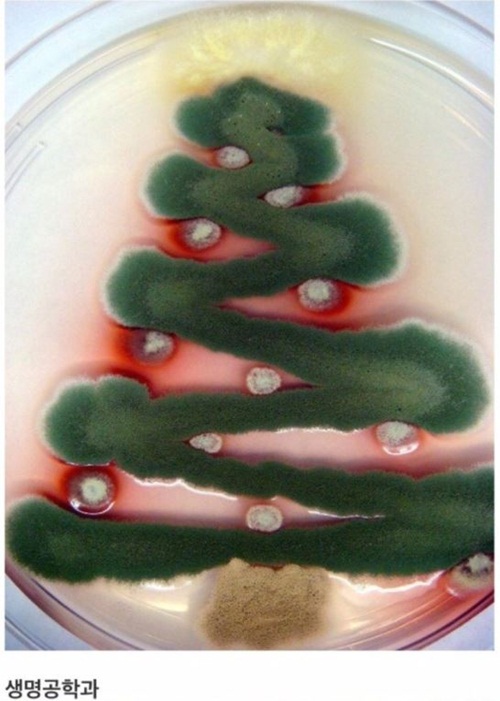
10

매년 크리스마스와 연말이 다가오면 거리 곳곳이 반짝이는 장식과 크리스마스 트리가 넘쳐난다.
이맘때쯤 되면 온라인상에서 늘 화제가 되는 사진이 있다.
바로 대학교 학과별 특징이 담긴 특별한 크리스마스트리다.
책으로 만들어진 국문학과, 문헌정보학과 트리부터 수술용 장갑으로 만들어진 의과 트리, 아름다운 우주의 모습이 담긴 천문학과 트리까지 하나하나 모두 눈길을 끈다.
9가지 학과별 크리스마스트리 사진을 감상해보자.
1. 국문학과
2. 문헌정보학과
3. 의과
4. 천문학과
5. 호텔조리학과
6. 컴퓨터공학과
7. 임상병리학과
8. 전자공학과
9. 생명공학과